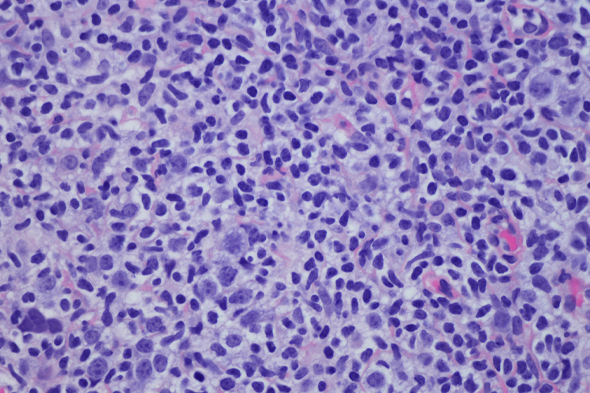
Role of Bruton Tyrosine Kinase in B-Cell Tumorigenesis

Expert Directory
Thomas J. Kipps, MD, PhD
Distinguished Professor of Medicine
Evelyn and Edwin Tasch Chair in Cancer Research
Deputy Director of Research Operations
Moores Cancer Center
UC San Diego Health
San Diego, CA
Thomas J. Kipps, MD, PhD, is Distinguished Professor of Medicine, Evelyn and Edwin Tasch Chair in Cancer Research, and Deputy Director of Research Operations at the UC San Diego Moores Cancer Center. He is internationally renowned for his translational research on immunologic approaches for the treatment of cancer and understanding the biologic mechanisms that contribute to cancer, in particular CLL. He is an award recipient with more than 30 years of experience in combining research and clinical care responsibilities and more than 400 peer-reviewed publications. He developed the humanized anti-ROR1 mAb cirmtuzumab.
Contributing Articles

Recommendations for Appropriate Use of Autologous Stem Cell Transplantation in a First-line Regimen for Mantle Cell Lymphoma
Role of Bruton Tyrosine Kinase in B-Cell Tumorigenesis

Treatment Recommendations for Patients With Asymptomatic Mantle Cell Lymphoma

Use of Prognostic Factors to Guide the Treatment of Patients With Mantle Cell Lymphoma


